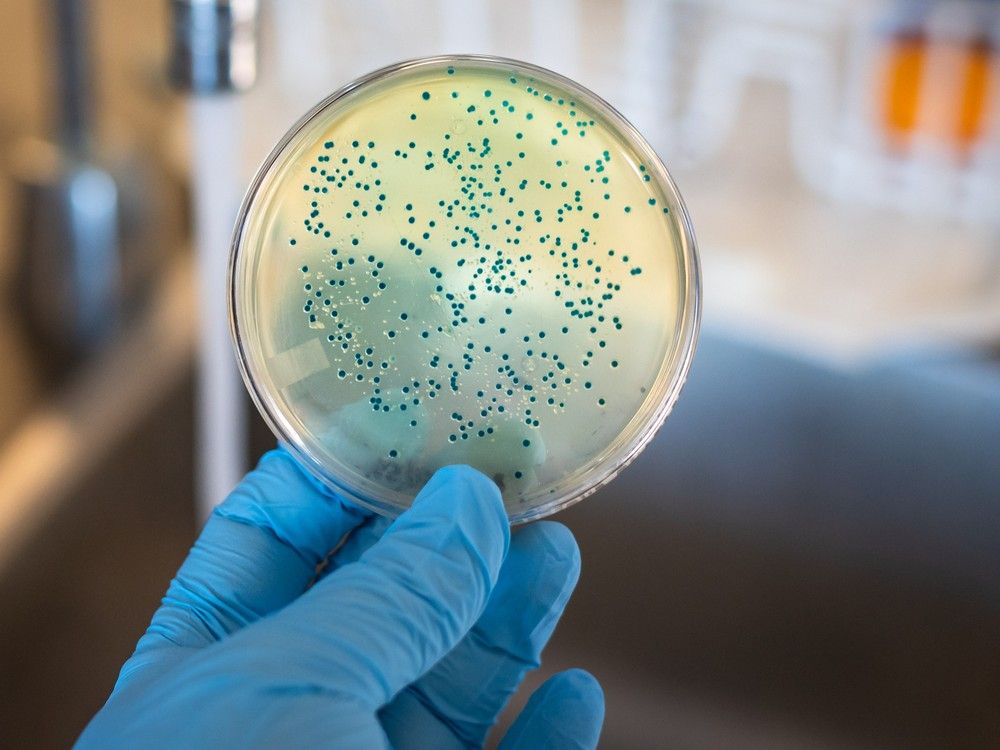
Alberta Health Services has declared an E. coli outbreak at six daycares and five other sites in the Calgary region, with 12 people admitted to hospital and many others seeking medical treatment.

The outbreak is linked to a shared central kitchen that provides lunches to all 11 affected child-care facilities

Article content
Parents of children who attend multiple Calgary daycares shuttered by an E. coli outbreak have been in and out of hospital through much of the weekend in what one mother described as a scary and traumatic situation.
As many as 50 children sought hospital care over the long weekend in relation to the outbreak tied to 11 child-care institutions in and around Calgary. The spread is linked to a shared central kitchen that provides lunches at all of the affected facilities.
Advertisement 2
Article content
Article content
As of Monday night, Alberta Health Services said 17 cases had been confirmed, and 12 people had been hospitalized. Health officials encouraged parents of children who attend the affected facilities to monitor symptoms.
AHS ordered Fueling Brains Academy locations Braeside, West 85th, New Brighton, Centennial, Bridgeland and McKnight to close until the situation is resolved.
Braineer Academy, Kidz Space, Little Oak Early Education (formerly Mangrove), Almond Branch School and Vik Academy in Okotoks have also been issued closure orders.
Hospital ‘packed’ with parents, toddlers
Katie McLean said her almost two-year-old daughter, who attends Fueling Brains Academy’s McKnight location, was sent home from a low fever on Thursday. Over the weekend, the girl’s symptoms progressed, and McLean noticed blood in her daughter’s increasingly frequent diarrhea — one of the primary severe symptoms associated with the infection, particularly the Shiga toxin-producing E. coli strain involved in this outbreak.
She called Health Link and was told to get the toddler tested for a bacterial infection.
Article content
Advertisement 3
Article content
“The swab came back positive for E. coli,” she said, “When we got to the (hospital) on Sunday, it was packed with parents and toddlers. And I overheard them talking about kind of what was going on for them, and I realized that all of their kids had the same symptoms.”
She said while other parents had heard from their daycares about the outbreak, she hadn’t received any information from Fuelling Brains Academy as of Sunday night. She received an email notifying her of the outbreak late Monday.
McLean said her daughter is confused and a bit scared by the repeated trips to the hospital. Her daughter, alongside the other children with the infection, will have to go to the hospital for daily blood work to monitor for potential complications.
“Getting the blood test and having to hold her down is obviously kind of traumatizing for all of us,” said McLean. “But obviously, the nurses and the care of the Children’s Hospital is just incredible.”
While symptoms tied to E. coli infections typically subside within 10 days, young children and seniors are at higher risk for complications.
Advertisement 4
Article content
Parents point finger at meatloaf
A Monday email to parents from Fueling Brains Academy, which was obtained by Postmedia, said the cause of the outbreak remains under investigation. They said AHS officials were looking to “identify whether there was a common food, water source or activity that led to this outbreak.”
“I want to express my deepest sympathy to all of our families, teachers and staff impacted by this health matter. Your speedy and complete recovery is top of mind for us,” wrote the academy’s CFO, Faisal Alimohd. “Additionally, we are committed to working alongside our families and the Ministry of Health to determine the root cause of this outbreak.”
But McLean said in talking with several other parents at the Alberta Children’s Hospital over the last couple of days, they have a good idea of the likely culprit for the outbreak. Parents compared notes as to what days their children attended and what they ate on the days they did attend.
“(It was) a pretty comprehensive investigation … We think it was the meatloaf on Tuesday,” she said, adding another group of families who went to the Peter Lougheed Centre came to the same conclusion. “They also landed on the meatloaf totally separately. I won’t be surprised at all if that’s what AHS’s investigation finds out.”
Advertisement 5
Article content
Other parents on social media have also noted the meatloaf as a potential cause.
In a letter from AHS to parents of children who attend Fueling Brains Academy’s McKnight location, also shared with Postmedia, Calgary zone medical officer of health Dr. Franco A. Rizzuti confirmed the outbreak is tied to the shared kitchen.
“It has been brought to my attention that your childcare facility … may have received food from a central kitchen that is linked to a Shiga toxin-producing E.coli (STEC) enteric (gastrointestinal) outbreak,” wrote the doctor in a Monday letter. “This kitchen has been closed, and out of an abundance of caution I have closed your childcare facility.”
“(AHS) has been working with the kitchen operator and your facility to reduce the possibility of transmission of this type of infection,” he added.
Rizzuti said if symptoms appear, it’s important for parents to keep children hydrated. He told parents if more severe symptoms like bloody diarrhea present, they should bring their children to the emergency room.
“Please encourage frequent handwashing with soap and water as part of your child’s regular hand hygiene practices to help stop the spread of infection,” said Rizzuti.
According to Health Canada, E. coli bacteria can spread through contact with infected people or infected animals, as well as contaminated surfaces, foods or liquids. Children, the elderly and the immunocompromised are at greater risk of complications.
Postmedia has reached out to Fueling Brains Academy for comment.
Twitter: @MichaelRdrguez
Article content
Parents concerned after E. coli outbreak at Calgary daycares - Calgary Herald
Read More

Comments
Postmedia is committed to maintaining a lively but civil forum for discussion and encourage all readers to share their views on our articles. Comments may take up to an hour for moderation before appearing on the site. We ask you to keep your comments relevant and respectful. We have enabled email notifications—you will now receive an email if you receive a reply to your comment, there is an update to a comment thread you follow or if a user you follow comments. Visit our Community Guidelines for more information and details on how to adjust your email settings.
Join the Conversation